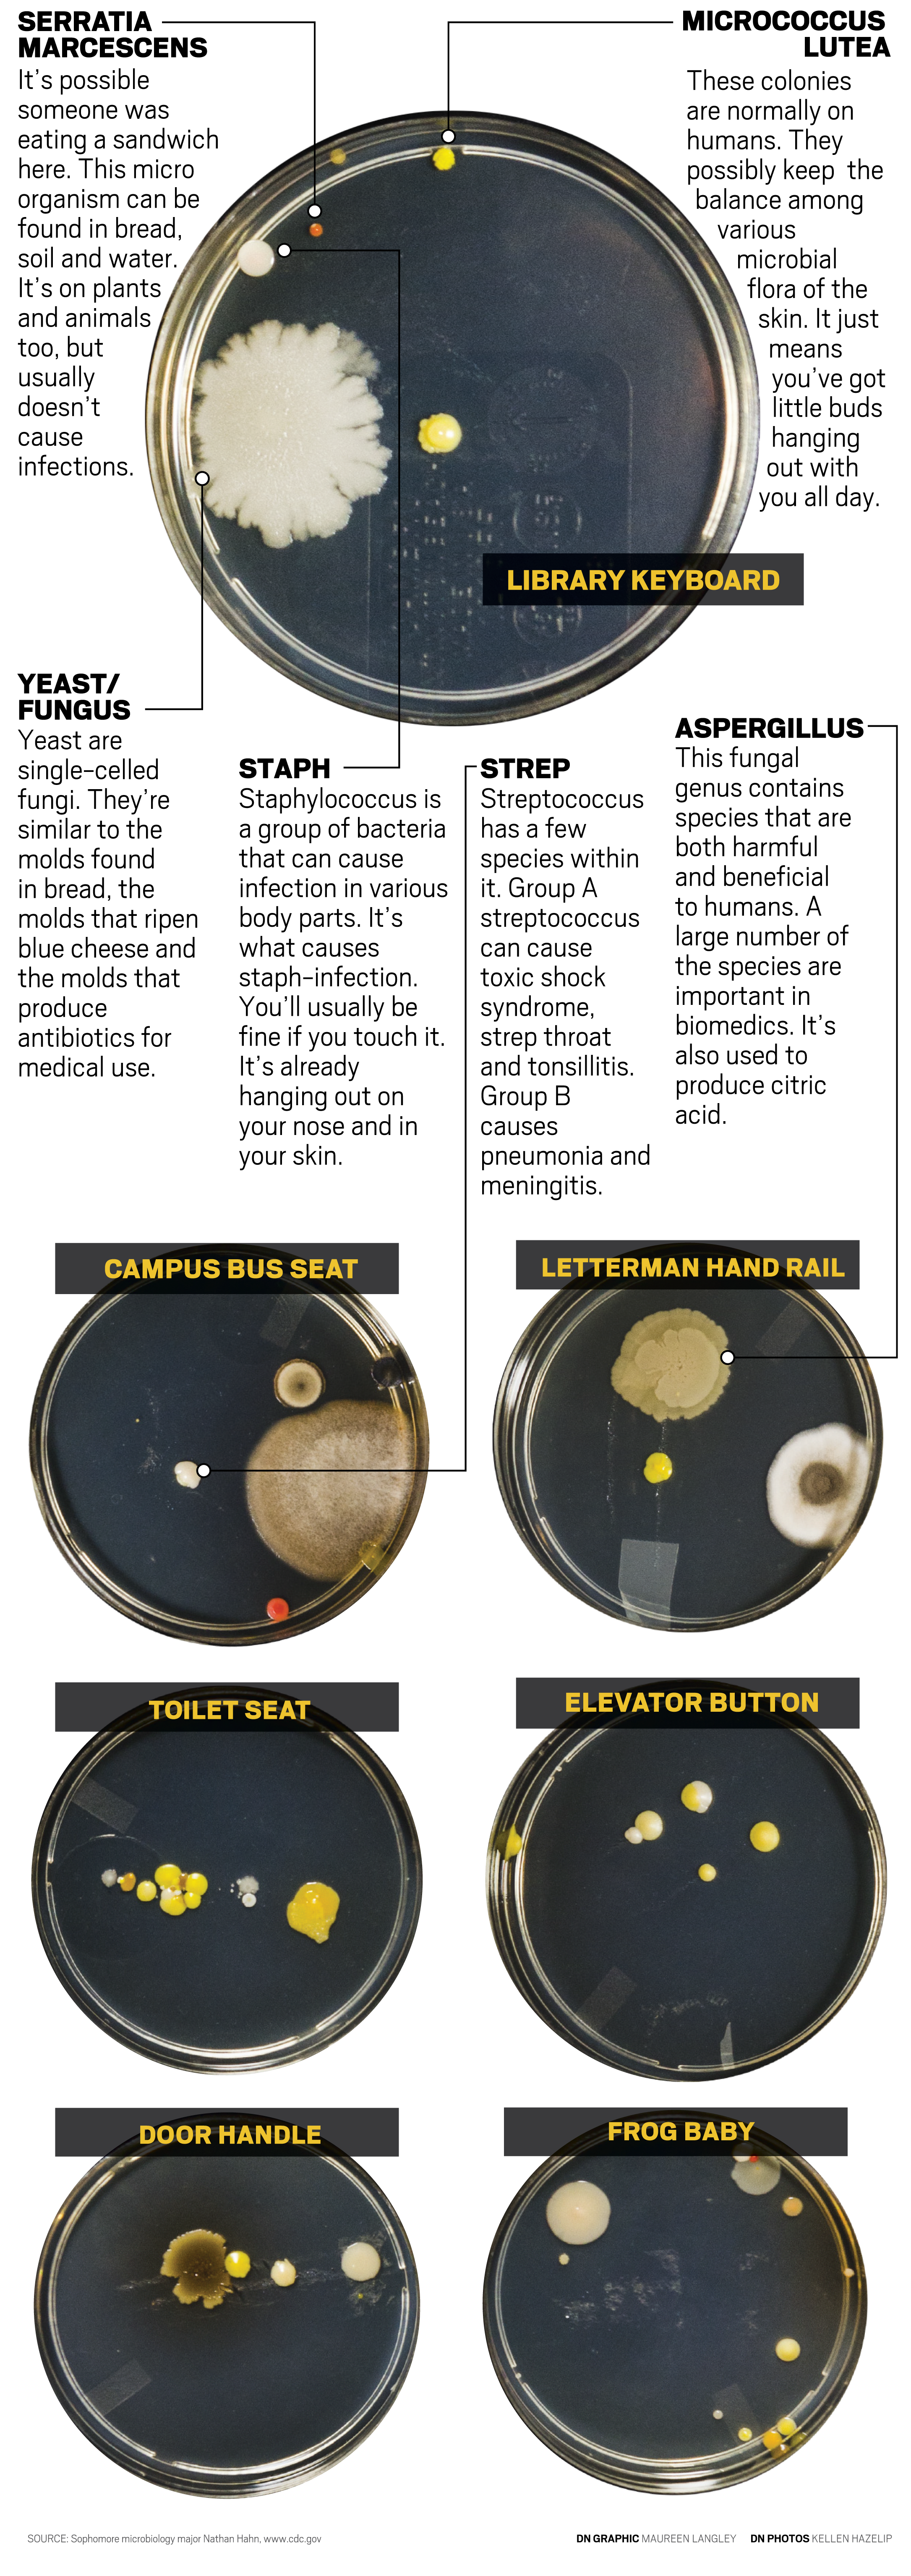

After growing swabs from seven campus locations, we found six main colonies of microorganisms and how they could harm you.
Read More
New owners of Mark III Taproom announce purchase of new location
By Trinity Rea / 17 hours agoThe new owners of Mark III Taproom have announced they’ve purchased a new location for the oldest gay bar in the state.
Ball State celebrates 2025 summer graduates at commencement ceremony
By Trinity Rea / YesterdayBall State's summer commencement honored graduates with speakers delivering messages of creativity, courage, and the power of vulnerability.
ICC: Defense letter confirms Indiana’s Camp Atterbury to be used for immigrant detention
By Indiana Capital Chronicle / YesterdayIndiana’s Camp Atterbury will be used to detain immigrant detainees under a new federal plan revealed this week by Defense Secretary Pete Hegseth.





